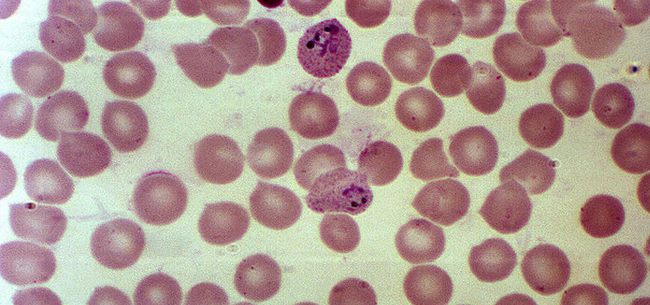

Российские и зарубежные химики заявляют о возможности существования двух стабильных соединений самого «ксенофобского» элемента – гелия, и экспериментально подтвердили существования одного из них – гелида натрия, говорится в статье, опубликованной…
Запись опубликована в “Наука”
Наука
Проект, рассчитанный на три года, будет способствовать развитию отечественного машиностроения, двигателестроения Ученые Уральского федерального университета (УрФУ) разработают новую аддитивную машину — промышленный 3D-принтер, которая позволит…
Ученые передали энергию на расстояние при помощи керамических резонаторов Ученые из Университета ИТМО разработали прототип устройства для беспроводной передачи энергии на основе диэлектрических дисков-резонаторов. Новая система позволяет на расстоянии…
Систему оказания медицинской помощи испытали на компьютерной модели Ученые из Университета ИТМО построили компьютерную модель системы для координации работы диспетчеров, бригад скорой помощи и сотрудников больниц. Согласно результатам…
Изобретение придаст поверхности астрономической оптики идеальную форму Во входящем в «Швабе» НПО «Оптика» разработана система адаптации высокоточных, в том числе внеосевых, асферических зеркал. С ее помощью поверхности…
Ученые из МГУ имени М.В. Ломоносова совместно с коллегами из других стран провели модификацию хитозанов (производных полисахаридов) и выяснили, что получившиеся соединения являются лучшими ингибиторами…
Технология позволит сократить время и затраты на обработку сварных соединений БАРНАУЛ, 27 января. /Корр. ТАСС Ксения Шубина/. Ученые Алтайского государственного технического университета (АлтГТУ) разработали технологию хладостойкой…
Ноябрьский новосибирский Академгородок встречал меня чистейшим сосновым воздухом, пушистым снегом и температурой минус 26 градусов. Сразу вспомнилось, как почти 35 лет назад я прилетел сюда с фанерным чемоданчиком…
В России создали андроида, который в перспективе сможет работать в сфере обслуживания и обучать людей В университете Иннополис (Татарстан) создали робота с человеческим лицом, который…
Специальные антитела блокируют эйфорию от героина Российские ученые разработали молекулу, которая блокирует удовольствие от наркотиков. К 2023 году она может стать основой первого отечественного лекарства…
Новость, которая может перевернуть жизнь миллионов людей по всему миру и избавить их от тяжелого недуга, до сегодняшнего дня считавшегося неизлечимым. Российские ученые создают первое…
Процесс сборки опытного образца первого российского автономного агротехнического робота для фестиваля ВУЗПРОМФЕСТ. У создателей Агробота в процессе разработки сайт agro-bot.ru, на котором можно будет в…
Исследователи из Томского политехнического университета совместно с питерскими и лондонскими коллегами разрабатывают особую технологию, позволяющую управлять мезенхимальными стволовыми клетками человека с помощью магнитного поля. Учёные рассчитывают,…
Химики из Новосибирского государственного университета и Института неорганической химии СО РАН разработали твёрдый раствор кобальта и иридия — новое соединение, которое может служить катализатором в…
Искусственно синтезированный элемент с атомным номером 115, который ранее был известен под названиями унунпентий и эка-висмут, официально получил название «московий». Об этом сообщается на сайте…
Ученые томского Института физики прочности и материаловедения (ИФПМ) совместно с Томским политехническим университетом и Чебоксарским предприятием «Сеспель» разработали технологию сварки высокопрочных сплавов, которая позволяет добиться…
В этом году планируется отправить на орбиту новый модуль МКС – «Наука». Это будет пятый модуль в российском сегменте станции. Жизнь экипажа на орбите станет…
В аэродинамической трубе малых скоростей Центрального аэрогидродинамического института имени профессора Н.Е. Жуковского (входит в НИЦ «Институт имени Н.Е.Жуковского») выполнена новая серия испытаний модели перспективного среднего транспортного двухфюзеляжного…
Специалисты разработали новый способ термической обработки стальных литых элементов тележки ж/д вагона путем их закалки. Это позволит увеличить прочность конструкции почти в 1,5 раза. Ученые из Национального исследовательского технологического…
Российские студенты создали полицейский электромотоцикл. Российские студенты создали полицейский электромотоцикл. Есть перспективы производства. На европейском конкурсе отечественная разработка была признана самой мощной и скоростной. http://strana-tv.ru
Создатели морозоустойчивого автомобильного топлива для Арктики из Томского политехнического университета (ТПУ) разработали технологию получения более дешевого бензина, что в будущем позволит экономно расходовать нефтяные запасы. «Учеными ТПУ…
Селекционеры считают, что высокое качество зерна вкупе с устойчивостью к болезням и засушливой погоде сделает сорт привлекательным для производителя В минувшем году сотрудники Сибирского научно…
Беспилотные «Матрешки», телевизионное оборудование нового поколения и порошковые протезы. Технопарк «Калибр» поражает своими уникальными разработками. https://russia.tv
Национальный исследовательский центр «Курчатовский институт». Здесь рождаются разработки, которые опережают время и переворачивают представление о реальности. Национальный исследовательский центр «Курчатовский институт». Его деятельность охватывает десятки…
Современный спорт немыслим без инноваций. К борьбе за высокий результат подключились медики, психологи, диетологи, инженеры. Они ищут новые подходы к тренировочному процессу. Результаты научных исследований…
Кристаллография может стать одним из самых перспективных направлений научной деятельности в мире В Москве открылся первый Российский кристаллографический конгресс «От конвергенции наук к природоподобным технологиям». Более…
Россия продвинулась еще на один шаг в создании уникального инженерного продукта – «двигателя второго этапа» для новейшего истребителя Т-50. Произвести такое изделие в чем-то даже…
Национальный исследовательский технологический университет МИСиС (НИТУ МИСиС) и Российский квантовый центр (РКЦ) открыли в Москве совместный научно-исследовательский проект «Квантовый центр» (КЦ). Новый центр станет крупнейшей профильной структурой…